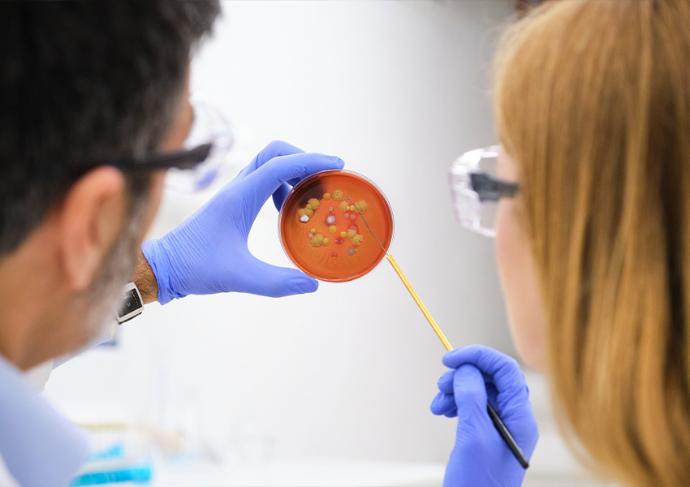
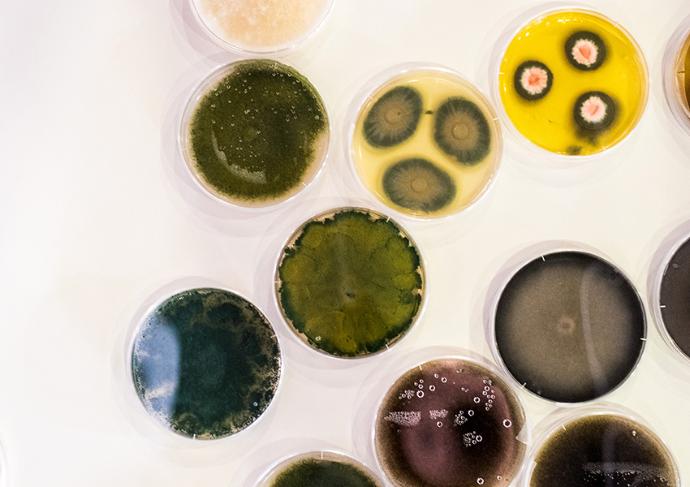
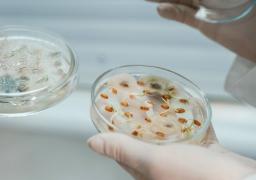
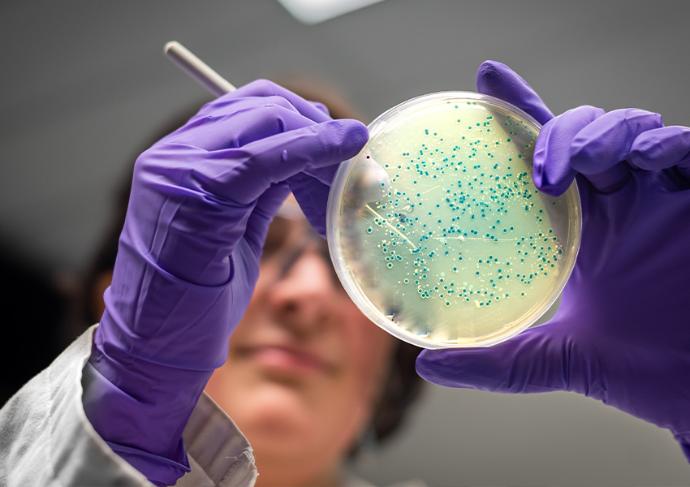

Yamato MBS Series Multi-Beads Shocker Tissue Homogenizer
A premium tissue homogenizer/pulverizer designed for fast processing of samples like yeast, bacteria, molds, and tough animal and plant tissues without the common damage these processes inflict on nucleic acids.
Process samples like leaves, roots, wheat, rice, and hair in seconds, not minutes.
Organ Tissue
Yeast
Rock
Bone
Plant tissue
Rubber
Minerals
Plastic
Cement
Much more...
Target Market
Bio Technology
Instantly crushes everything from yeast to animal and plant tissues and bones in a frozen disposable tube

Virus Infected Organ
Low temperature

Mouse Femur
Liquid Nitrogen

Yeast
4°C / Liquid nitrogen

Fresh Plant Leaf
Liquid Nitrogen
Application
- Elucidation of the pathology of COVID-19 and vaccine development
- Regenerative medicine research (stem cell extraction)
- Sample preparation for omics analysis DNA identification
- Nucleic acid extraction of pathogenic viruses and microorganisms
- Extraction of active viruses and microorganisms
- Detection of pathogens in seafood
- High-purity RNA extraction from clinical specimens
- Sample preparation for analysis of trace elements In food
- ChIP-Seq analysis
- Plant quarantine
- Freezing and pulverizing of animal tissues, plant tissues, and microorganisms
Geo Science
Accelerate preparation of precise analytical samples, including rocks and minerals!

Peridotite
Room temperature

Chart
Room temperature

Core
Room temperature

Agate
Room temperature
Application
- Isotope ratio analysis
- ICP-MS analysis
- X-ray fluorescence analysis
- Zircon separation
- Nanoparticle preparation
Analytical Science
From rocks, rubber, and plastics to biological tissue, this greatly reduces sample preparation time and cost

Slate
Room temperature

Film Coated Tablets
Liquid Nitrogen
Application
- X-ray fluorescence analysis
- Preparation of materials for ICP-MS analysis
- Analysis of asbestos-containing building materials
- Soil nutrient analysis (collection of samples under 2mm)
- Creation of nanoparticles from pharmaceutical and industrial dye stuff (cold crushing)
- Analysis of harmful substances contained in resins (formaldehyde, etc.)
- Analysis of RoHS regulations
Material Science
Proven track record in accelerating research and development of next generation ceramic and energy materials

Geocement
Room temperature

Ceramic
Room temperature

Film Coated Tablets
Room temperature
Application
- Development of next-generation battery materials
- Reaction development
- Other next generation material development
Organ tissue
Bone
Yeast
Plant tissue
Rock
Rubber
Minerals
Much more...
Cement
Plastic
Target Market
Biotechnology
Instantly crushes everything from yeast to animal and plant tissues and bones in a frozen disposable tube.

Virus Infected Organ
Low temperature

Mouse Femur
Liquid Ntrogen

Yeast
4°C / Liquid nitrogen

Fresh Plant Leaf
Liquid nitrogen
Applications
- Elucidation of the pathology of COVID-19 and vaccine development
- Regenerative medicine research (stem cell extraction)
- Sample preparation for omics analysis DNA identification
- Nucleic acid extraction of pathogenic viruses and microorganisms
- Extraction of active viruses and microorganisms
- Detection of pathogens in seafood
- High-purity RNA extraction from clinical specimens
- Sample preparation for analysis of trace elements In food
- ChIP-Seq analysis
- Plant quarantine
- Freezing and pulverizing of animal tissues, plant tissues, and microorganisms
Earth Sciences
Accelerate preparation of precise analytical samples, including rocks and minerals.

Peridotite
Room temperature

Chart
Room temperature

Core
Room temperature

Agate
Room temperature
Applications
- Isotope ratio analysis
- ICP-MS analysis
- X-ray fluorescence analysis
- Zircon separation
- Nanoparticle preparation
Analytical Science
From rocks, rubber, and plastics to biological tissue, this greatly reduces sample preparation time and cost.

Slate
Room temperature

Film Coated Tablets
Liquid Nitrogen
Applications
- X-ray fluorescence analysis
- Preparation of materials for ICP-MS analysis
- Analysis of asbestos-containing building materials
- Soil nutrient analysis (collection of samples under 2mm)
- Creation of nanoparticles from pharmaceutical and industrial dye stuff (cold crushing)
- Analysis of harmful substances contained in resins (formaldehyde, etc.)
- Analysis of RoHS regulations
Material Science
Proven track record in accelerating research and development of next generation ceramic and energy materials.

Geocement
Room temperature

Ceramic
Room temperature

Hardened Concrete
Room temperature
Applications
- Development of next-generation battery materials
- Reaction development
- Other next generation material development
MBS at the 77th Annual Scientific Conference of American Academy of Forensic Sciences in Baltimore, Maryland
Premium tissue homogenizer / pulverizer for up to 5X more nucleic acids downstream
Fast average runtime of 10-20 seconds vs competing models at 7-10 minutes.
Pulverize hair for analysis in 10 seconds.
Easily dust leaves, roots, wheat, rice, and other difficult plant samples.
Pulverize film coated tablets in 30 seconds or less.
Prepare teeth, organs, bones for analysis in under 15 seconds.
Tissue homogenizer / pulverizer for up to 5X more nucleic acids downstream
Fast average runtime of 10-20 seconds vs competing models at 7-10 minutes.
Pulverize hair for analysis in 10 seconds.
Easily dust leaves, roots, wheat, rice, and other difficult plant samples.
Pulverize film coated tablets in 30 seconds or less.
Prepare teeth, organs, bones for analysis in under 15 seconds.
Eliminate the sample damage caused by friction-heat in your current sample homogenization process
Eliminate the sample damage caused by friction-heat in your current sample homogenization process
Heat generation during homogenization dramatically impacts sample integrity across applications.
Temperature effects cascade throughout downstream workflows, amplifying negative impacts.
The human consequences extend beyond technical failures to careers, finances, and patient outcomes.
Reduced sample damage represents an ethical imperative in your lab today.
Heat generation during homogenization dramatically impacts sample
integrity across applications.
Temperature effects cascade
throughout downstream
workflows, amplifying negative impacts.
The human consequences extend
beyond technical failures
to careers, finances, and patient outcomes.
Reduced sample damage
represents an ethical imperative
in your lab today.
Why is up to 5X more DNA/RNA recovery a big deal?
More sensitivity. More accuracy.
- Low-quality DNA leads to sequencing artifacts, PCR dropouts, and missed mutations.
- More RNA means better gene expression profiling, especially for rare transcripts.
Difficult samples aren’t so difficult anymore.
- Samples that were previously too degraded, small, or complex can now yield enough nucleic acids for meaningful analysis.
Does budget grow on trees?
- Technicians need fewer reagents and fewer replicates, saving money on kits, sequencing, and analysis.
Sample waste is incredibly inefficient.
- Some samples (like biopsies, ancient DNA, or rare organisms) are irreplaceable. More efficient DNA extraction means less sample is needed per experiment.
Why is up to 5X more DNA/RNA recovery a big deal?


More sensitivity. More accuracy.
- Low-quality DNA leads to sequencing artifacts, PCR dropouts, and missed mutations.
- More RNA means better gene expression profiling, especially for rare transcripts.


Difficult samples aren’t so difficult anymore.
- Samples that were previously too degraded, small, or complex can now yield enough nucleic acids for meaningful analysis.


Does budget grow on trees?
- Technicians need fewer reagents and fewer replicates, saving money on kits, sequencing, and analysis.


Sample waste is incredibly inefficient.
- Some samples (like biopsies, ancient DNA, or rare organisms) are irreplaceable. More efficient DNA extraction means less sample is needed per experiment.
How can your lab benefit by investing in a Multi-Beads Shocker tissue homogenizer / pulverizer?
1. More reliable data and less variation

Many experiments fail or produce inconclusive results due to low nucleic acid yields from your existing bead tissue homogenizer.

Higher recovery means stronger, more reproducible data, leading to higher confidence in conclusions and fewer false negatives.

Researchers can run fewer replicates and still get statistically significant results.
How can your lab benefit by investing in a Multi-Beads Shocker tissue homogenizer / pulverizer?
1. More reliable data and less variation

Many experiments fail or produce inconclusive results due to low nucleic acid yields from your existing bead tissue homogenizer.

Higher recovery means stronger, more reproducible data, leading to higher confidence in conclusions and fewer false negatives.

Researchers can run fewer replicates and still get statistically significant results.
2. Make work with ultra-low biomass samples manageable
Some samples naturally contain very little DNA/RNA, like environmental samples from deep-sea sediments, permafrost, or ancient DNA. Biomedical samples like single-cell extractions
or rare biopsies. And pathogens or contaminants that exist at trace levels in food, water, or soil.
With higher recovery, these samples become viable for study, even when starting material is limited.
2. Make work with ultra-low biomass samples manageable
Some samples naturally contain very little DNA/RNA, like environmental samples from deep-sea sediments, permafrost, or ancient DNA. Biomedical samples like single-cell extractions or rare biopsies. And pathogens or contaminants that exist at trace levels in food, water, or soil.
With higher recovery, these samples become viable for study, even when starting material is limited.
3. Reduce the amount sample input your bead mill homogenizer / pulverizer needs
Scientists can extract enough DNA/RNA from a smaller sample size, reducing the need for…

Larger tissue biopsies in clinical or forensic research (preserving valuable or limited material).

More invasive sampling in animal and plant studies (less impact on living organisms).

Costly large-volume sampling in environmental DNA (eDNA) and microbial research.
4. Shrink the impact of amplification bias and artifacts
In low-yield samples, you often rely on PCR amplification to increase DNA/RNA quantity.
This can introduce biases, where certain fragments are overrepresented or errors are introduced.
Higher initial recovery reduces reliance on amplification, leading to cleaner, more representative genetic profiles.
5. Make other technologies you invest in more feasible
Many other techniques you invest in require high-purity, high-yield nucleic acids.
Single-cell RNA sequencing (scRNA-seq)
Long-read sequencing
CRISPR-based diagnostics
6. Perform better microbial and metagenomic studies
Microbiome and environmental DNA (eDNA) research depend on representative microbial diversity.
Many existing lysis/homogenization methods favor stronger cell walls, skewing community profiles.
A gentler, high-recovery homogenization process preserves rare and fragile species, giving a more accurate snapshot of microbial ecosystems.
7. Unlock greater sensitivity in diagnostics and forensics
Many diagnostic tests and forensic analyses rely on detecting trace amounts of DNA or RNA.
Higher recovery allows…

Earlier disease detection in liquid biopsies or viral load monitoring.

More reliable crime scene DNA analysis from degraded or limited evidence.

Food and water safety testing at lower detection thresholds.
8. Reduce the cost of NGS and other downstream workflows
DNA sequencing costs scale with library prep, reagents, and sequencing depth.
When you recover more nucleic acid, you need…

Fewer library enrichment kits, saving on expensive reagents.

Lower sequencing depth, reducing run costs.

Fewer runs, because you get more usable data per run.
9. Make sample storage and biobanks far more efficient
- You never know when your sample will be needed in the future. Many labs store extracted DNA/RNA for those down-the-road scenarios.
- Higher initial yields mean more aliquots, allowing samples to be used across multiple studies without depletion.
- This is particularly valuable in biobanks, where sample conservation is critical for longitudinal studies.
An increase in DNA/RNA recovery directly impacts research accuracy, cost efficiency, and the ability to work with challenging samples.
In any field where you use a lab tissue homogenizer, this advantage makes experiments cheaper, more reliable, and more feasible.

How is the heat from your lab tissue homogenizer / pulverizer impacting samples and outcomes in your lab?
Heat during cell lysis can destroy up to 80% of valuable biomolecules in your samples. For irreplaceable specimens, the loss is permanent.
Your current method:
- Degrades nucleic acids, reducing DNA/RNA yields by 60-80%.
- Denatures proteins, compromising downstream analysis.
- Alters metabolite profiles, creating misleading results.
- Introduces artifacts that can invalidate data.
Learn more and make your process bulletproof with our experts’ free guide.
How is the heat from your lab tissue homogenizer / pulverizer impacting samples and outcomes in your lab?
Heat during cell lysis can destroy up to 80% of valuable biomolecules in your samples. For irreplaceable specimens, the loss is permanent.
Your current method:
- Degrades nucleic acids, reducing DNA/RNA yields by 60-80%.
- Denatures proteins, compromising downstream analysis.
- Alters metabolite profiles, creating misleading results.
- Introduces artifacts that can invalidate data.
Learn more and make your process bulletproof with our experts’ free guide.

What determines your tissue homogenizer price and total cost of ownership?
Choosing the tissue homogenizer that gives your lab the greatest cost-benefit requires looking beyond that purchase price. Take your free copy of this eBook to get a handle on the factors that determine your true return on investment.
Learn how different technologies impact:
- Sample throughput and research timelines
- Extraction yields and downstream success rates
- Personnel time allocation and expertise requirements
- Long-term maintenance and operational expenses
How biologists benefit from the Multi Beads Shocker homogenizer / pulverizer
Biologists working in molecular biology, genetics, pathology, and biomedical research need high-quality nucleic acids for various downstream analyses. Common applications where the Multi Beads Shocker helps improve these downstream applications…
Genomics and transcriptomics
- Researchers studying gene expression, mutations, or epigenetics need as much undamaged DNA/RNA as possible to get accurate sequencing results.
- More recovered RNA leads to better qPCR, RT-PCR, RNA-seq, and microarray performance.
- Less degradation reduces the need for amplification, preserving sample integrity.
Cancer and disease research
- Some samples, like tumors or biopsies, are scarce or fragile. Higher nucleic acid recovery means researchers can perform more assays per sample without needing more tissue.
Microbiome and metagenomics
- When studying gut microbiota or other microbial communities, a gentler homogenization process preserves microbial DNA diversity rather than favoring hardier species that survive harsher lysis.
Stem cell and developmental biology
- Precise analysis of embryonic or stem cell RNA relies on high yields of intact mRNA, which is prone to degradation during homogenization.
How environmental scientists benefit from the Multi Beads Shocker homogenizer / pulverizer
Environmental scientists working in ecology, soil science, forensic science, and bioremediation often deal with challenging sample types like soil, water biofilms, plant tissues, and
Metagenomic and microbial studies
- Extracting DNA from soil, sediments, or biofilms is notoriously difficult. Many standard methods recover DNA unevenly, leading to biased microbial community profiles.
- A plant tissue homogenizer that preserves DNA integrity means better sequencing accuracy and a more representative snapshot of environmental microbiomes.

Environmental forensics and contamination monitoring
- Scientists tracking pathogens in water or pollutants in soil rely on DNA-based methods to detect rare or low-abundance species.
- More DNA recovery = higher sensitivity when detecting contaminants, pathogens, or invasive species.

Agricultural and plant genomics
-
When analyzing stress responses in plants or soil microbiomes, a gentler lysis process preserves nucleic acids better, improving gene expression analysis.
Climate change and biodiversity research
- Studies tracking genetic adaptation or species distribution in extreme environments (permafrost, deep-sea sediments) benefit from higher DNA recovery rates, especially from low-biomass samples.
How biomedical and clinical researchers benefit from the Multi Beads Shocker homogenizer / pulverizer
Biomedical and clinical researchers rely on high-yield, high-purity DNA and RNA from human samples to study diseases, develop treatments, and refine diagnostic tools. Many of these samples (like biopsies, blood, or tissue extracts) are limited, delicate, or prone to degradation, making maximum nucleic acid recovery valuable.

Enables more tests per sample, preserving irreplaceable patient materials.

Reduces sequencing and reagent costs,
since fewer amplification steps are needed.

Improves sensitivity and reproducibility, in molecular diagnostics.

Supports breakthroughs in personalized medicine,
where data quality is critical.
Cancer and disease research
- Tumor biopsies and patient-derived samples often have scarce, fragile RNA that degrades quickly. More intact RNA means better gene expression analysis, enabling researchers to track mutations, identify biomarkers, and refine targeted therapies.
- Higher recovery also improves liquid biopsy testing, making non-invasive diagnostics more reliable.
Infectious disease studies and pathogen detection
- Virology and bacteriology labs rely on RNA from viruses and bacteria for PCR and sequencing. A gentler homogenization process means higher viral RNA yield, improving sensitivity in COVID-19, influenza, or emerging disease research.
- This also benefits antibiotic resistance studies, where small microbial samples must yield enough DNA for whole-genome sequencing.
Personalized and regenerative medicine
- Precision medicine depends on patient-specific genetic data, requiring high-quality DNA and RNA for sequencing and molecular profiling.
How agricultural and plant scientists benefit from the Multi Beads Shocker homogenizer / pulverizer

Improves accuracy in plant gene expression studies,
leading to faster breeding cycles.

Enables better monitoring of soil and plant health,
driving precision agriculture.

Enhances pathogen detection sensitivity,
helping protect crops and food supply.

Reduces sample loss,
preserving valuable specimens from rare or endangered plant species.
Plant and agricultural researchers face a unique challenge when extracting DNA and RNA from plant tissues. Rigid cell walls, polysaccharide contamination, and inhibitors interfere with downstream applications. Many plant samples yield low-quality or degraded nucleic acids, making gene expression studies and genomic research difficult.
Researchers to extract more genetic material with less damage and contamination, leading to better results in…Crop breeding and genetic improvement
- Higher DNA yields enable faster screening of plant traits, helping breeders identify disease resistance, drought tolerance, and yield-enhancing genes.
- More RNA recovery means better transcriptome analysis, improving our understanding of how plants respond to stress, climate change, and pathogens.
GMO research and regulatory testing
- More efficient DNA extraction supports faster and more reliable identification of genetic modifications in crops.
- Regulatory bodies and seed companies benefit from higher DNA recovery, ensuring better traceability of GMOs in food supply chains.
Soil and rhizosphere microbiome studies
- Plant roots interact with complex microbial communities that influence growth, nutrient uptake, and disease resistance.
- Higher microbial DNA yield allows for more complete metagenomic analysis, leading to better insights into soil health, biofertilizers, and plant-microbe interactions.
Plant disease diagnosis and pathogen detection
- Detecting plant pathogens (fungal, bacterial, viral) in infected leaves, stems, or roots depends on extracting high-quality pathogen DNA or RNA.
- A more efficient homogenization process improves early disease detection, allowing for quicker intervention and crop protection.
How veterinary and animal health scientists benefit from the Multi Beads Shocker homogenizer / pulverizer

Improves disease diagnostics, allowing earlier and more precise treatment for pets and livestock.

Enhances genetic selection in breeding programs, supporting animal health and productivity.

Boosts conservation efforts, making it easier to study and protect endangered species.

Provides better insights into the animal microbiome,
improving veterinary nutrition and medicine.
Veterinary and animal health researchers rely on DNA and RNA extraction from blood, tissues, and microbiomes to study diseases, genetics, and treatments in animals. However, extracting high-quality nucleic acids from animal samples is often challenging due to low DNA yields, inhibitors in biological fluids, and sample degradation.
With more DNA/RNA researchers obtain cleaner, higher-yield extractions, improving research in…
Infectious disease research and veterinary diagnostics
- Detecting viral and bacterial infections in livestock, pets, and wildlife depends on extracting pathogen DNA or RNA from blood, saliva, and tissue samples.
- More RNA recovery improves early disease detection, making diagnostics for canine parvovirus, bovine tuberculosis, avian flu, and zoonotic diseases like rabies more reliable.
Livestock and breeding programs
- Understanding genetic traits in cattle, poultry, swine, and equine species is essential for breeding healthier, more resilient animals.
- More DNA means better genomic selection for disease resistance, milk production, muscle growth, and fertility.
Wildlife and conservation genetics
- Studying endangered species, population genetics, and disease spread in wild animals requires extracting DNA from hair, feces, and other non-invasive samples.
- Higher recovery improves species tracking, biodiversity monitoring, and forensic wildlife investigations.
Gut microbiome and veterinary nutrition
- Research on probiotics, digestion, and microbiome health in animals relies on recovering bacterial DNA from fecal samples.
- More DNA means better gut microbiome profiling, helping veterinarians understand nutritional deficiencies, metabolic diseases, and immune function.
How forensic scientists benefit from the Multi Beads Shocker homogenizer / pulverizer

Increases the chance of obtaining a usable DNA profile from degraded or trace samples.

Enhances forensic reliability, reducing false negatives and incomplete profiles.

Improves identification accuracy, in criminal cases, missing person investigations, and disaster victim recovery.

Supports anti-poaching and wildlife crime investigations, protecting endangered species.
Forensic scientists rely on DNA and RNA analysis to solve crimes, identify remains, and track biological evidence. However, forensic samples are often degraded, limited in quantity, or contaminated, making DNA extraction difficult and unreliable. Maximizing DNA recovery is crucial to ensuring that evidence holds up in investigations and legal proceedings.
A tissue homogenizer that recovers 5X more DNA/RNA significantly improves forensic workflows, enabling:
Crime scene DNA analysis
- Bloodstains, hair follicles, skin cells, and touch DNA contain only trace amounts of DNA.
- Higher recovery increases the likelihood of obtaining a complete genetic profile, improving identification accuracy.
Cold case investigations and degraded sample recovery
- Older forensic evidence often has partially degraded DNA, making sequencing and profiling difficult.
- A more efficient homogenization process allows forensic scientists to recover usable DNA from decades-old evidence, helping solve cold cases.
Human identification and mass disaster victim recovery
- In mass casualty events, natural disasters, or war crime investigations, DNA is sometimes the only means of identifying victims.
- Improved DNA recovery enhances the ability to identify remains from burned, decomposed, or skeletal remains.
Wildlife forensics and anti-poaching investigations
- Illegally traded ivory, horns, skins, and meat can be traced through DNA evidence.
- Higher recovery ensures accurate species identification, helping enforce anti-poaching laws.
Biosecurity and bioterrorism forensics
- Forensic labs investigating bioterror threats, hazardous biological agents, or emerging pathogens require high-sensitivity DNA extraction.
- More efficient sample processing allows for faster detection of biological threats.
How food safety and microbiology researchers benefit from the Multi Beads Shocker homogenizer / pulverizer

Enhances pathogen detection, reducing contamination risks in food production.

Improves metagenomic analysis,
leading to better food microbiome research.

Speeds up quality control testing, ensuring safer and more consistent food products.

Supports allergen and GMO testing, helping manufacturers meet regulatory standards.
Food safety and microbiology researchers rely on DNA and RNA extraction from food, surfaces, and microbial cultures to detect pathogens, monitor food quality, and prevent contamination. However, extracting nucleic acids from food matrices - especially meats, dairy, grains, and processed foods - can be challenging due to inhibitors, low bacterial loads, and sample complexity.
Avoiding sample damage during pulverization means you perform better in…
Pathogen detection and foodborne illness prevention
- Detecting E. coli, Salmonella, Listeria, and Campylobacter in food requires high-yield microbial DNA extraction.
- Higher recovery improves qPCR and sequencing sensitivity, reducing the risk of false negatives in contamination testing.
Food microbiome and spoilage studies
- Understanding the microbial communities in fermented foods, fresh produce, and packaged goods requires metagenomic analysis.
- More DNA means better profiling of spoilage organisms, probiotics, and foodborne pathogens.
Quality control in food production and processing
- Routine food safety testing in meat processing plants, dairy facilities, and beverage production requires consistent and reliable nucleic acid extraction.
- Higher recovery ensures faster, more reliable microbial screening, reducing contamination risks.
Allergen and GMO testing
- Food manufacturers must verify that products meet regulatory standards for allergen labeling and GMO content.
- A more efficient homogenization process improves detection of trace DNA from allergens (e.g., peanut, soy, gluten) and genetically modified organisms.
Environmental surface testing in food facilities
- Food processing plants test for microbial contamination on equipment, surfaces, and air samples.
- Higher DNA recovery allows for more sensitive environmental monitoring, reducing foodborne illness outbreaks.
How biotech and pharmaceutical scientists benefit from the Multi Beads Shocker homogenizer / pulverizer

Speeds up drug and vaccine development,
particularly for RNA-based therapeutics.

Enhances gene editing efficiency, supporting CRISPR and genetic engineering research.

Improves cell and gene therapy workflows,
increasing reproducibility and reliability.

Strengthens biologic drug quality control, ensuring compliance and safety in pharmaceutical manufacturing.
Biotech and pharmaceutical researchers rely on high-yield, high-purity DNA and RNA for drug development, biologics production, and precision medicine. Many workflows including gene therapy, CRISPR research, and mRNA-based drug development require exceptionally clean and intact nucleic acids. However, traditional homogenization methods often result in fragmentation, contamination, or low recovery, which can compromise downstream processes.
The Multi Beads Shocker allows biotech and pharmaceutical scientists to…
Accelerate drug development and precision medicine
- Higher RNA yield improves biomarker discovery, target validation, and pharmacogenomics.
- Better nucleic acid integrity supports mRNA vaccine development and RNA-based therapeutics (e.g., siRNA, antisense oligonucleotides).
Improve CRISPR and genetic engineering applications
- More intact DNA enables better plasmid construction, gene insertion, and gene editing efficiency.
- Higher RNA yields enhance single-cell RNA sequencing (scRNA-seq), which is crucial for cell therapy development.
Enhance cell and gene therapy research
- Many cell therapies depend on viral vectors for gene delivery. Higher nucleic acid recovery ensures more efficient viral packaging.
- Improved RNA integrity enables better characterization of stem cells, CAR-T cells, and engineered tissues.
Optimize bioprocessing and fermentation studies
- Many biotech applications involve engineered microbes, mammalian cell cultures, or yeast-based protein production.
- More DNA recovery ensures better tracking of genetic modifications, while more RNA allows for better control of protein expression and metabolic pathways.
Improve pharmaceutical quality control and biosimilar development
- High DNA/RNA recovery allows for more precise contamination detection in biologic drug manufacturing.
- Better nucleic acid recovery improves comparability testing between biosimilars and their reference biologics.
How marine biologists and oceanographers benefit from the Multi Beads Shocker homogenizer / pulverizer

Improves eDNA sensitivity, making biodiversity monitoring more accurate.

Enhances marine microbiome studies, leading to better understanding of ocean health.

Strengthens coral conservation efforts,
helping track stress responses and disease outbreaks.

Increases pathogen detection sensitivity,
protecting marine life and fisheries.
Marine biologists and oceanographers study marine ecosystems, biodiversity, and environmental changes using DNA and RNA from water, sediments, and marine organisms. However, marine samples often contain low biomass, degraded nucleic acids, and environmental inhibitors like salts and organic matter, making nucleic acid extraction difficult.
By recovering up to 5X more DNA/RNA, researchers can extract more genetic material from challenging marine samples, improving research in…
Environmental DNA (eDNA) and biodiversity monitoring
- Many marine species leave behind trace amounts of DNA in water, making eDNA analysis essential for tracking rare or elusive organisms.
- Higher DNA recovery improves species identification accuracy, helping scientists monitor fish populations, coral reef health, and ecosystem changes.
Microbial oceanography and marine microbiome studies
- Marine ecosystems depend on complex microbial communities, including plankton, deep-sea bacteria, and symbiotic algae.
- More RNA means better transcriptomics, allowing researchers to study how microbes respond to climate change, ocean acidification, and pollution.
Coral reef conservation and stress response studies
- Coral reefs are highly sensitive to temperature changes, disease, and pollutants. Studying coral DNA and RNA helps researchers assess stress markers and resilience.
- Higher nucleic acid recovery improves gene expression analysis, making it easier to track bleaching events and disease outbreaks.
Deep-sea and extreme environment research
- Deep-sea sediments and hydrothermal vent samples contain low-biomass DNA that is often difficult to extract.
- More efficient DNA recovery helps scientists study extremophiles, novel marine species, and deep-sea ecosystems.
Tracking marine pathogens and harmful algal blooms
- Some marine diseases (e.g., oyster herpesvirus, sea star wasting disease) and harmful algal blooms (red tides, cyanobacteria) devastate marine life.
- Higher DNA/RNA yields enable faster, more sensitive detection, helping scientists track outbreaks and predict their impact.
How synthetic biologists and bioengineers benefit from the Multi Beads Shocker homogenizer / pulverizer

Enhances gene editing success rates, making CRISPR modifications more efficient.

Improves metabolic engineering workflows,
increasing bioproduct yields.

Strengthens biosensor reliability,
improving environmental and medical diagnostics.

Supports synthetic cell research,
enabling better control over artificial biological systems
Synthetic biologists and bioengineers design and engineer new biological systems, genetically modified organisms (GMOs), and metabolic pathways for a wide range of applications, from biofuels and sustainable materials to biosensors and gene circuits. However, working with engineered cells often requires high-yield, high-purity DNA and RNA to ensure reliable genetic modifications and controlled expression.
The Multi Beads Shocker helps improve research in…
Plasmid and genome engineering
- Synthetic biology relies on precise DNA modifications for designing plasmids, inserting genes, and editing bacterial or yeast genomes.
- Higher DNA recovery improves CRISPR efficiency, cloning success rates, and gene circuit stability.
Metabolic engineering and biomanufacturing
- Many bioengineering applications involve modifying microbes to produce bioplastics, pharmaceuticals, or biofuels.
- More RNA recovery means better transcriptomics, allowing researchers to optimize enzyme expression and metabolic pathways for higher yields.
Biosensor and bioremediation development
- Scientists engineer cells to detect toxins, heavy metals, or pollutants in the environment.
- Improved DNA recovery ensures better tracking of genetic modifications, making biosensors more reliable in real-world applications.
Gene circuit optimization and synthetic cell development
- Building synthetic cells or artificial gene networks requires precise control of transcription and translation.
- More RNA means better measurement of gene expression, enabling fine-tuning of genetic circuits for predictable behavior.
Cell-free systems and protein engineering
- Cell-free synthetic biology extracts DNA and RNA to drive reactions outside of living cells, useful for in vitro protein synthesis, drug discovery, and biosensing.
- Higher nucleic acid yields improve reaction efficiency, making cell-free systems more cost-effective.
How archeogeneticists and paleogenomic researchers benefit from the Multi Beads Shocker homogenizer / pulverizer

Maximizes recovery from rare and fragile samples,
preventing irreversible data loss.

Improves sequencing accuracy for extinct and ancient species,
helping reconstruct evolutionary histories.

Enhances pathogen detection in historical remains,
offering insights into ancient epidemics.

Supports climate and ecosystem reconstructions, advancing our understanding of prehistoric life.
Archeogenetics and paleogenomics focus on recovering and analyzing ancient DNA from fossils, bones, and preserved biological material to uncover evolutionary history, human migration patterns, and extinct species. However, ancient DNA is often highly degraded, fragmented, and present in extremely low concentrations, making successful extraction difficult.
Preserving more sample leads to better results in…
Human evolution and ancestry studies
- Studying DNA from ancient human remains helps scientists trace migration patterns, interbreeding events, and genetic adaptations over thousands of years.
- Higher DNA recovery improves sequencing success for Neanderthal, Denisovan, and early Homo sapiens genomes.
Extinct species reconstruction and conservation genetics
- Extracting DNA from preserved remains (bones, teeth, mummified tissue) helps reconstruct the genomes of extinct species like woolly mammoths, saber-toothed cats, and giant ground sloths.
- More DNA yield enables better phylogenetic analysis, helping scientists understand how extinct species relate to modern animals.
Ancient pathogen and epidemic research
- Historical outbreaks of bubonic plague, tuberculosis, or influenza can be traced by analyzing DNA from skeletal remains of past civilizations.
- Higher DNA yield increases detection sensitivity, improving our understanding of how ancient diseases shaped human history.
Environmental aDNA and ice core studies
- DNA preserved in ice cores, sediments, and peat bogs provides a window into prehistoric ecosystems, climate shifts, and biodiversity changes.
- More DNA recovery allows scientists to reconstruct ancient plant and microbial communities, revealing long-term environmental trends.
Museum specimen and cultural artifact analysis
- Many historical artifacts like mummies, preserved textiles, parchment, and relics contain trace amounts of DNA that can provide clues about their origins.
- Higher nucleic acid yield increases the success rate of forensic archeology and historical reconstructions.
How biodefense and bioterrorism experts benefit from the Multi Beads Shocker bead mill homogenizer / pulverizer

Increases sensitivity in detecting bioweapons and emerging diseases, improving response times.

Enhances forensic investigations,
allowing better tracking of biological threats.

Improves environmental biosurveillance, reducing the risk of undetected outbreaks.

Speeds up countermeasure development, helping create vaccines and treatments faster.
Biodefense and bioterrorism experts work to detect, identify, and mitigate biological threats, including weaponized pathogens, emerging infectious diseases, and environmental biohazards. Speed, sensitivity, and accuracy are critical in this field, as rapid identification can mean the difference between containment and widespread outbreak. However, many biological threats exist in trace amounts, and traditional DNA/RNA extraction methods may not recover enough genetic material for reliable detection.
The Multi Beads Shocker can improve your capabilities in…
Human evolution and ancestry studies
- Studying DNA from ancient human remains helps scientists trace migration patterns, interbreeding events, and genetic adaptations over thousands of years.
- Higher DNA recovery improves sequencing success for Neanderthal, Denisovan, and early Homo sapiens genomes.
Extinct species reconstruction and conservation genetics
- Extracting DNA from preserved remains (bones, teeth, mummified tissue) helps reconstruct the genomes of extinct species like woolly mammoths, saber-toothed cats, and giant ground sloths.
- More DNA yield enables better phylogenetic analysis, helping scientists understand how extinct species relate to modern animals.
Ancient pathogen and epidemic research
- Historical outbreaks of bubonic plague, tuberculosis, or influenza can be traced by analyzing DNA from skeletal remains of past civilizations.
- Higher DNA yield increases detection sensitivity, improving our understanding of how ancient diseases shaped human history.
Environmental aDNA and ice core studies
- DNA preserved in ice cores, sediments, and peat bogs provides a window into prehistoric ecosystems, climate shifts, and biodiversity changes.
- More DNA recovery allows scientists to reconstruct ancient plant and microbial communities, revealing long-term environmental trends.
Museum specimen and cultural artifact analysis
- Many historical artifacts like mummies, preserved textiles, parchment, and relics contain trace amounts of DNA that can provide clues about their origins.
- Higher nucleic acid yield increases the success rate of forensic archeology and historical reconstructions.
What determines your tissue homogenizer price and total cost of ownership?
Choosing the tissue homogenizer that gives your lab the greatest cost-benefit requires looking beyond that purchase price. Take your free copy of this eBook to get a handle on the factors that determine your true return on investment.
Learn how different technologies impact:
- Sample throughput and research timelines
- Extraction yields and downstream success rates
- Personnel time allocation and expertise requirements
- Long-term maintenance and operational expenses
3. Reduce the amount sample input your bead mill homogenizer / pulverizer needs
Scientists can extract enough DNA/RNA from a smaller sample size, reducing the need for…

Larger tissue biopsies in clinical or forensic research (preserving valuable or limited material).

More invasive sampling in animal and plant studies (less impact on living organisms).

Costly large-volume sampling in environmental DNA (eDNA) and microbial research.
4. Shrink the impact of amplification bias and artifacts
In low-yield samples, you often rely on PCR amplification to increase DNA/RNA quantity.
This can introduce biases, where certain fragments are overrepresented or errors are introduced.
Higher initial recovery reduces reliance on amplification, leading to cleaner, more representative genetic profiles.
5. Make other technologies you invest in more feasible
Many other techniques you invest in require high-purity, high-yield nucleic acids.
Single-cell RNA sequencing (scRNA-seq)
Long-read sequencing
CRISPR-based diagnostics
6. Perform better microbial and metagenomic studies
Microbiome and environmental DNA (eDNA) research depend on representative microbial diversity.
Many existing lysis/homogenization methods favor stronger cell walls, skewing community profiles.
A gentler, high-recovery homogenization process preserves rare and fragile species, giving a more accurate snapshot of microbial ecosystems.
7. Unlock greater sensitivity in diagnostics and forensics
Many diagnostic tests and forensic analyses rely on detecting trace amounts of DNA or RNA.
Higher recovery allows…

Earlier disease detection in liquid biopsies or viral load monitoring.

More reliable crime scene DNA analysis from degraded or limited evidence.

Food and water safety testing at lower detection thresholds.
8. Reduce the cost of NGS and other downstream workflows
DNA sequencing costs scale with library prep, reagents, and sequencing depth.
When you recover more nucleic acid, you need…

Fewer library enrichment kits, saving on expensive reagents.

Lower sequencing depth, reducing run costs.

Fewer runs, because you get more usable data per run.
9. Make sample storage and biobanks far more efficient
- You never know when your sample will be needed in the future. Many labs store extracted DNA/RNA for those down-the-road scenarios.
- Higher initial yields mean more aliquots, allowing samples to be used across multiple studies without depletion.
- This is particularly valuable in biobanks, where sample conservation is critical for longitudinal studies.
An increase in DNA/RNA recovery directly impacts research accuracy, cost efficiency, and the ability to work with challenging samples.
In any field where you use a lab tissue homogenizer, this advantage makes experiments cheaper, more reliable, and more feasible.
How biologists benefit from the Multi Beads Shocker homogenizer / pulverizer
Biologists working in molecular biology, genetics, pathology, and biomedical research need high-quality nucleic acids for various downstream analyses. Common applications where the Multi Beads Shocker helps improve these downstream applications…
Genomics and transcriptomics
- Researchers studying gene expression, mutations, or epigenetics need as much undamaged DNA/RNA as possible to get accurate sequencing results.
- More recovered RNA leads to better qPCR, RT-PCR, RNA-seq, and microarray performance.
- Less degradation reduces the need for amplification, preserving sample integrity.
Cancer and disease research
- Some samples, like tumors or biopsies, are scarce or fragile. Higher nucleic acid recovery means researchers can perform more assays per sample without needing more tissue.
Microbiome and metagenomics
-
When studying gut microbiota or other microbial communities, a gentler homogenization process preserves microbial DNA diversity rather than favoring hardier species that survive harsher lysis.
Stem cell and developmental biology
- Precise analysis of embryonic or stem cell RNA relies on high yields of intact mRNA, which is prone to degradation during homogenization.
How environmental scientists benefit from the Multi Beads Shocker homogenizer / pulverizer
Environmental scientists working in ecology, soil science, forensic science, and bioremediation often deal with challenging sample types like soil, water biofilms, plant tissues, and
Metagenomic and microbial Studies
- Extracting DNA from soil, sediments, or biofilms is notoriously difficult. Many standard methods recover DNA unevenly, leading to biased microbial community profiles.
- A plant tissue homogenizer that preserves DNA integrity means better sequencing accuracy and a more representative snapshot of environmental microbiomes.
Environmental forensics and contamination monitoring
- Scientists tracking pathogens in water or pollutants in soil rely on DNA-based methods to detect rare or low-abundance species.
- More DNA recovery = higher sensitivity when detecting contaminants, pathogens, or invasive species.
Agricultural and plant genomics
-
When analyzing stress responses in plants or soil microbiomes, a gentler lysis process preserves nucleic acids better, improving gene expression analysis.
Climate change and biodiversity research
- Studies tracking genetic adaptation or species distribution in extreme environments (permafrost, deep-sea sediments) benefit from higher DNA recovery rates, especially from low-biomass samples.
How biomedical and clinical researchers benefit from the Multi Beads Shocker homogenizer / pulverizer
Biomedical and clinical researchers rely on high-yield, high-purity DNA and RNA from human samples to study diseases, develop treatments, and refine diagnostic tools.
Many of these samples (like biopsies, blood, or tissue extracts) are limited, delicate, or prone to degradation, making maximum nucleic acid recovery valuable.

Enables more tests per sample, preserving irreplaceable patient materials.

Enables more tests per sample, preserving irreplaceable patient materials.

Reduces sequencing and reagent costs, since fewer amplification steps are needed.

Reduces sequencing and reagent costs, since fewer amplification steps are needed.

Improves sensitivity and reproducibility, in molecular diagnostics.

Improves sensitivity and reproducibility, in molecular diagnostics.

Enables more tests per sample, preserving irreplaceable patient materials.
Cancer and disease research
- Tumor biopsies and patient-derived samples often have scarce, fragile RNA that degrades quickly. More intact RNA means better gene expression analysis, enabling researchers to track mutations, identify biomarkers, and refine targeted therapies.
- Higher recovery also improves liquid biopsy testing, making non-invasive diagnostics more reliable.
Infectious disease studies and pathogen detection
- Virology and bacteriology labs rely on RNA from viruses and bacteria for PCR and sequencing. A gentler homogenization process means higher viral RNA yield, improving sensitivity in COVID-19, influenza, or emerging disease research.
- This also benefits antibiotic resistance studies, where small microbial samples must yield enough DNA for whole-genome sequencing.
Personalized and regenerative medicine
- Precision medicine depends on patient-specific genetic data, requiring high-quality DNA and RNA for sequencing and molecular profiling.
- Regenerative medicine, including stem cell research and tissue engineering, benefits from higher nucleic acid recovery to track differentiation pathways and optimize therapeutic development.
Clinical diagnostics and biomarker discovery
- Many diagnostics rely on detecting rare mutations, epigenetic modifications, or disease-associated RNA transcripts. More RNA means better sensitivity and accuracy in qPCR, NGS, and microarray analysis.
- This is particularly valuable in neurological disease research, where biomarkers for Alzheimer’s, Parkinson’s, or ALS can be difficult to detect in small samples.
How agricultural and plant scientists benefit from the Multi Beads Shocker homogenizer / pulverizer

Improves accuracy in plant gene expression studies, leading to faster breeding cycles.

Improves accuracy in plant gene expression studies, leading to faster breeding cycles.

Improves accuracy in plant gene expression studies, leading to faster breeding cycles.
Enables better monitoring of soil and plant health, driving precision agriculture.

Enables better monitoring of soil and plant health, driving precision agriculture.

Enhances pathogen detection sensitivity, helping protect crops and food supply.

Enhances pathogen detection sensitivity, helping protect crops and food supply.

Reduces sample loss, preserving valuable specimens from rare or endangered plant species.

Reduces sample loss, preserving valuable specimens from rare or endangered plant species.
Plant and agricultural researchers face a unique challenge when extracting DNA and RNA from plant tissues. Rigid cell walls, polysaccharide contamination, and inhibitors interfere with downstream applications. Many plant samples yield low-quality or degraded nucleic acids, making gene expression studies and genomic research difficult.
Researchers to extract more genetic material with less damage and contamination, leading to better results in…
Crop breeding and genetic improvement
- Higher DNA yields enable faster screening of plant traits, helping breeders identify disease resistance, drought tolerance, and yield-enhancing genes.
- More RNA recovery means better transcriptome analysis, improving our understanding of how plants respond to stress, climate change, and pathogens.
GMO research and regulatory testing
- More efficient DNA extraction supports faster and more reliable identification of genetic modifications in crops.
- Regulatory bodies and seed companies benefit from higher DNA recovery, ensuring better traceability of GMOs in food supply chains.
Soil and rhizosphere microbiome studies
- Plant roots interact with complex microbial communities that influence growth, nutrient uptake, and disease resistance.
- Higher microbial DNA yield allows for more complete metagenomic analysis, leading to better insights into soil health, biofertilizers, and plant-microbe interactions.
How veterinary and animal health scientists benefit from the Multi Beads Shocker homogenizer / pulverizer

Improves disease diagnostics, allowing earlier and more precise treatment for pets and livestock.

Improves disease diagnostics, allowing earlier and more precise treatment for pets and livestock.

Enhances genetic selection in breeding programs, supporting animal health and productivity.

Enhances genetic selection in breeding programs, supporting animal health and productivity.

Boosts conservation efforts, making it easier to study and protect endangered species.

Boosts conservation efforts, making it easier to study and protect endangered species.

Provides better insights into the animal microbiome, improving veterinary nutrition and medicine.
Provides better insights into the animal microbiome, improving veterinary nutrition and medicine.
Veterinary and animal health researchers rely on DNA and RNA extraction from blood, tissues, and microbiomes to study diseases, genetics, and treatments in animals. However, extracting high-quality nucleic acids from animal samples is often challenging due to low DNA yields, inhibitors in biological fluids, and sample degradation.
With more DNA/RNA researchers obtain cleaner, higher-yield extractions, improving research in…
Infectious disease research and veterinary diagnostics
- Detecting viral and bacterial infections in livestock, pets, and wildlife depends on extracting pathogen DNA or RNA from blood, saliva, and tissue samples.
- More RNA recovery improves early disease detection, making diagnostics for canine parvovirus, bovine tuberculosis, avian flu, and zoonotic diseases like rabies more reliable.
Livestock and breeding programs
- Understanding genetic traits in cattle, poultry, swine, and equine species is essential for breeding healthier, more resilient animals.
- More DNA means better genomic selection for disease resistance, milk production, muscle growth, and fertility.
Wildlife and conservation genetics
- Studying endangered species, population genetics, and disease spread in wild animals requires extracting DNA from hair, feces, and other non-invasive samples.
- Higher recovery improves species tracking, biodiversity monitoring, and forensic wildlife investigations.
Gut microbiome and veterinary nutrition
- Research on probiotics, digestion, and microbiome health in animals relies on recovering bacterial DNA from fecal samples.
- More DNA means better gut microbiome profiling, helping veterinarians understand nutritional deficiencies, metabolic diseases, and immune function.
How forensic scientists benefit from the Multi Beads Shocker homogenizer / pulverizer

Increases the chance of obtaining a usable DNA profile from degraded or trace samples.

Increases the chance of obtaining a usable DNA profile from degraded or trace samples.

Enhances forensic reliability, reducing false negatives and incomplete profiles.

Enhances forensic reliability, reducing false negatives and incomplete profiles.

Improves identification accuracy in criminal cases, missing person investigations, and disaster victim recovery.

Improves identification accuracy in criminal cases, missing person investigations, and disaster victim recovery.

Supports anti-poaching and wildlife crime investigations, protecting endangered species.

Supports anti-poaching and wildlife crime investigations, protecting endangered species.
Forensic scientists rely on DNA and RNA analysis to solve crimes, identify remains, and track biological evidence. However, forensic samples are often degraded, limited in quantity, or contaminated, making DNA extraction difficult and unreliable. Maximizing DNA recovery is crucial to ensuring that evidence holds up in investigations and legal proceedings.
A tissue homogenizer that recovers 5X more DNA/RNA significantly improves forensic workflows, enabling:
Crime scene DNA analysis
- Bloodstains, hair follicles, skin cells, and touch DNA contain only trace amounts of DNA.
- Higher recovery increases the likelihood of obtaining a complete genetic profile, improving identification accuracy.
Cold case investigations and degraded sample recovery
- Older forensic evidence often has partially degraded DNA, making sequencing and profiling difficult.
- A more efficient homogenization process allows forensic scientists to recover usable DNA from decades-old evidence, helping solve cold cases.
Human identification and mass disaster victim recovery
- In mass casualty events, natural disasters, or war crime investigations, DNA is sometimes the only means of identifying victims.
- Improved DNA recovery enhances the ability to identify remains from burned, decomposed, or skeletal remains.
Wildlife forensics and anti-poaching investigations
- Illegally traded ivory, horns, skins, and meat can be traced through DNA evidence.
- Higher recovery ensures accurate species identification, helping enforce anti-poaching laws.
Biosecurity and bioterrorism forensics
- Forensic labs investigating bioterror threats, hazardous biological agents, or emerging pathogens require high-sensitivity DNA extraction.
- More efficient sample processing allows for faster detection of biological threats.
How food safety and microbiology researchers benefit from the Multi Beads Shocker homogenizer / pulverizer

Enhances pathogen detection, reducing contamination risks in food production.

Enhances pathogen detection, reducing contamination risks in food production.

Improves metagenomic analysis, leading to better food microbiome research.

Improves metagenomic analysis, leading to better food microbiome research.

Speeds up quality control testing, ensuring safer and more consistent food products.

Speeds up quality control testing, ensuring safer and more consistent food products.

Supports allergen and GMO testing, helping manufacturers meet regulatory standards.

Supports allergen and GMO testing, helping manufacturers meet regulatory standards.
Food safety and microbiology researchers rely on DNA and RNA extraction from food, surfaces, and microbial cultures to detect pathogens, monitor food quality, and prevent contamination. However, extracting nucleic acids from food matrices - especially meats, dairy, grains, and processed foods - can be challenging due to inhibitors, low bacterial loads, and sample complexity.
Avoiding sample damage during pulverization means you perform better in…
Pathogen detection and foodborne illness prevention
- Detecting E. coli, Salmonella, Listeria, and Campylobacter in food requires high-yield microbial DNA extraction.
- Higher recovery improves qPCR and sequencing sensitivity, reducing the risk of false negatives in contamination testing.
Food microbiome and spoilage studies
- Understanding the microbial communities in fermented foods, fresh produce, and packaged goods requires metagenomic analysis.
- More DNA means better profiling of spoilage organisms, probiotics, and foodborne pathogens.
Quality control in food production and processing
- Routine food safety testing in meat processing plants, dairy facilities, and beverage production requires consistent and reliable nucleic acid extraction.
- Higher recovery ensures faster, more reliable microbial screening, reducing contamination risks.
Allergen and GMO testing
- Food manufacturers must verify that products meet regulatory standards for allergen labeling and GMO content.
- A more efficient homogenization process improves detection of trace DNA from allergens (e.g., peanut, soy, gluten) and genetically modified organisms.
Environmental surface testing in food facilities
- Food processing plants test for microbial contamination on equipment, surfaces, and air samples.
- Higher DNA recovery allows for more sensitive environmental monitoring, reducing foodborne illness outbreaks.
How biotech and pharmaceutical scientists benefit from the Multi Beads Shocker homogenizer / pulverizer

Speeds up drug and vaccine development, particularly for RNA-based therapeutics.

Speeds up drug and vaccine development, particularly for RNA-based therapeutics.

Enhances gene editing efficiency, supporting CRISPR and genetic engineering research.

Enhances gene editing efficiency, supporting CRISPR and genetic engineering research.

Improves cell and gene therapy workflows,
increasing reproducibility and reliability.

Improves cell and gene therapy workflows,
increasing reproducibility and reliability.

Strengthens biologic drug quality control, ensuring compliance and safety in pharmaceutical manufacturing.

Strengthens biologic drug quality control, ensuring compliance and safety in pharmaceutical manufacturing.
Biotech and pharmaceutical researchers rely on high-yield, high-purity DNA and RNA for drug development, biologics production, and precision medicine. Many workflows including gene therapy, CRISPR research, and mRNA-based drug development require exceptionally clean and intact nucleic acids. However, traditional homogenization methods often result in fragmentation, contamination, or low recovery, which can compromise downstream processes.
The Multi Beads Shocker allows biotech and pharmaceutical scientists to…
Accelerate drug development and precision medicine
- Higher RNA yield improves biomarker discovery, target validation, and pharmacogenomics.
- Better nucleic acid integrity supports mRNA vaccine development and RNA-based therapeutics (e.g., siRNA, antisense oligonucleotides).
Improve CRISPR and genetic engineering applications
- More intact DNA enables better plasmid construction, gene insertion, and gene editing efficiency.
- Higher RNA yields enhance single-cell RNA sequencing (scRNA-seq), which is crucial for cell therapy development.
Enhance cell and gene therapy research
- Many cell therapies depend on viral vectors for gene delivery. Higher nucleic acid recovery ensures more efficient viral packaging.
- Improved RNA integrity enables better characterization of stem cells, CAR-T cells, and engineered tissues.
Optimize bioprocessing and fermentation studies
- Many biotech applications involve engineered microbes, mammalian cell cultures, or yeast-based protein production.
- More DNA recovery ensures better tracking of genetic modifications, while more RNA allows for better control of protein expression and metabolic pathways.
Improve pharmaceutical quality control and biosimilar development
- High DNA/RNA recovery allows for more precise contamination detection in biologic drug manufacturing.
- Better nucleic acid recovery improves comparability testing between biosimilars and their reference biologics.
How marine biologists and oceanographers benefit from the Multi Beads Shocker homogenizer / pulverizer

Improves eDNA sensitivity, making biodiversity monitoring more accurate.

Improves eDNA sensitivity, making biodiversity monitoring more accurate.

Enhances marine microbiome studies, leading to better understanding of ocean health.

Enhances marine microbiome studies, leading to better understanding of ocean health.

Strengthens coral conservation efforts, helping track stress responses and disease outbreaks.

Strengthens coral conservation efforts, helping track stress responses and disease outbreaks.

Increases pathogen detection sensitivity, protecting marine life and fisheries.

Increases pathogen detection sensitivity, protecting marine life and fisheries.
Marine biologists and oceanographers study marine ecosystems, biodiversity, and environmental changes using DNA and RNA from water, sediments, and marine organisms. However, marine samples often contain low biomass, degraded nucleic acids, and environmental inhibitors like salts and organic matter, making nucleic acid extraction difficult.
By recovering up to 5X more DNA/RNA, researchers can extract more genetic material from challenging marine samples, improving research in…
Environmental DNA (eDNA) and biodiversity monitoring
- Many marine species leave behind trace amounts of DNA in water, making eDNA analysis essential for tracking rare or elusive organisms.
- Higher DNA recovery improves species identification accuracy, helping scientists monitor fish populations, coral reef health, and ecosystem changes.
Microbial oceanography and marine microbiome studies
- Marine ecosystems depend on complex microbial communities, including plankton, deep-sea bacteria, and symbiotic algae.
- More RNA means better transcriptomics, allowing researchers to study how microbes respond to climate change, ocean acidification, and pollution.
Coral reef conservation and stress response studies
- Coral reefs are highly sensitive to temperature changes, disease, and pollutants. Studying coral DNA and RNA helps researchers assess stress markers and resilience.
- Higher nucleic acid recovery improves gene expression analysis, making it easier to track bleaching events and disease outbreaks.
Deep-sea and extreme environment research
- Deep-sea sediments and hydrothermal vent samples contain low-biomass DNA that is often difficult to extract.
- More efficient DNA recovery helps scientists study extremophiles, novel marine species, and deep-sea ecosystems.
Tracking marine pathogens and harmful algal blooms
- Some marine diseases (e.g., oyster herpesvirus, sea star wasting disease) and harmful algal blooms (red tides, cyanobacteria) devastate marine life.
- Higher DNA/RNA yields enable faster, more sensitive detection, helping scientists track outbreaks and predict their impact.
How synthetic biologists and bioengineers benefit from the Multi Beads Shocker homogenizer / pulverizer

Enhances gene editing success rates, making CRISPR modifications more efficient.

Enhances gene editing success rates, making CRISPR modifications more efficient.

Improves metabolic engineering workflows, increasing bioproduct yields.

Improves metabolic engineering workflows, increasing bioproduct yields.

Strengthens biosensor reliability, improving environmental and medical diagnostics.

Strengthens biosensor reliability, improving environmental and medical diagnostics.

Supports synthetic cell research, enabling better control over artificial biological systems

Supports synthetic cell research, enabling better control over artificial biological systems
Synthetic biologists and bioengineers design and engineer new biological systems, genetically modified organisms (GMOs), and metabolic pathways for a wide range of applications, from biofuels and sustainable materials to biosensors and gene circuits. However, working with engineered cells often requires high-yield, high-purity DNA and RNA to ensure reliable genetic modifications and controlled expression.
The Multi Beads Shocker helps improve research in…
Plasmid and genome engineering
- Synthetic biology relies on precise DNA modifications for designing plasmids, inserting genes, and editing bacterial or yeast genomes.
- Higher DNA recovery improves CRISPR efficiency, cloning success rates, and gene circuit stability.
Metabolic engineering and biomanufacturing
- Many bioengineering applications involve modifying microbes to produce bioplastics, pharmaceuticals, or biofuels.
- More RNA recovery means better transcriptomics, allowing researchers to optimize enzyme expression and metabolic pathways for higher yields.
Gene circuit optimization and synthetic cell development
- Building synthetic cells or artificial gene networks requires precise control of transcription and translation.
- More RNA means better measurement of gene expression, enabling fine-tuning of genetic circuits for predictable behavior.
Cell-free systems and protein engineering
- Cell-free synthetic biology extracts DNA and RNA to drive reactions outside of living cells, useful for in vitro protein synthesis, drug discovery, and biosensing.
- Higher nucleic acid yields improve reaction efficiency, making cell-free systems more cost-effective.
How archeogeneticists and paleogenomic researchers benefit from the Multi Beads Shocker homogenizer / pulverizer

Maximizes recovery from rare and fragile samples, preventing irreversible data loss.

Maximizes recovery from rare and fragile samples, preventing irreversible data loss.

Improves sequencing accuracy for extinct and ancient species, helping reconstruct evolutionary histories.

Improves sequencing accuracy for extinct and ancient species, helping reconstruct evolutionary histories.

Enhances pathogen detection in historical remains, offering insights into ancient epidemics.

Enhances pathogen detection in historical remains, offering insights into ancient epidemics.

Supports climate and ecosystem reconstructions, advancing our understanding of prehistoric life.

Supports climate and ecosystem reconstructions, advancing our understanding of prehistoric life.
Archeogenetics and paleogenomics focus on recovering and analyzing ancient DNA from fossils, bones, and preserved biological material to uncover evolutionary history, human migration patterns, and extinct species. However, ancient DNA is often highly degraded, fragmented, and present in extremely low concentrations, making successful extraction difficult.
Preserving more sample leads to better results in…
Human evolution and ancestry studies
- Studying DNA from ancient human remains helps scientists trace migration patterns, interbreeding events, and genetic adaptations over thousands of years.
- Higher DNA recovery improves sequencing success for Neanderthal, Denisovan, and early Homo sapiens genomes.
Extinct species reconstruction and conservation genetics
- Extracting DNA from preserved remains (bones, teeth, mummified tissue) helps reconstruct the genomes of extinct species like woolly mammoths, saber-toothed cats, and giant ground sloths.
- More DNA yield enables better phylogenetic analysis, helping scientists understand how extinct species relate to modern animals.
Ancient pathogen and epidemic research
- Historical outbreaks of bubonic plague, tuberculosis, or influenza can be traced by analyzing DNA from skeletal remains of past civilizations.
- Higher DNA yield increases detection sensitivity, improving our understanding of how ancient diseases shaped human history.
Environmental aDNA and ice core studies
- DNA preserved in ice cores, sediments, and peat bogs provides a window into prehistoric ecosystems, climate shifts, and biodiversity changes.
- More DNA recovery allows scientists to reconstruct ancient plant and microbial communities, revealing long-term environmental trends.
Museum specimen and cultural artifact analysis
- Many historical artifacts like mummies, preserved textiles, parchment, and relics contain trace amounts of DNA that can provide clues about their origins.
- Higher nucleic acid yield increases the success rate of forensic archeology and historical reconstructions.
How biodefense and bioterrorism experts benefit from the Multi Beads Shocker bead mill homogenizer / pulverizer

Increases sensitivity in detecting bioweapons and emerging diseases, improving response times.

Increases sensitivity in detecting bioweapons and emerging diseases, improving response times.

Enhances forensic investigations, allowing better tracking of biological threats.

Enhances forensic investigations, allowing better tracking of biological threats.

Improves environmental biosurveillance, reducing the risk of undetected outbreaks.

Improves environmental biosurveillance, reducing the risk of undetected outbreaks.

Speeds up countermeasure development, helping create vaccines and treatments faster.

Speeds up countermeasure development, helping create vaccines and treatments faster.
Biodefense and bioterrorism experts work to detect, identify, and mitigate biological threats, including weaponized pathogens, emerging infectious diseases, and environmental biohazards. Speed, sensitivity, and accuracy are critical in this field, as rapid identification can mean the difference between containment and widespread outbreak. However, many biological threats exist in trace amounts, and traditional DNA/RNA extraction methods may not recover enough genetic material for reliable detection.
The Multi Beads Shocker can improve your capabilities in…
Early detection of biological threats
- Anthrax, ricin, smallpox, Ebola, and synthetic bioweapons require ultra-sensitive detection methods to prevent outbreaks.
- More DNA/RNA recovery enables faster PCR-based identification of biological agents in air, water, or contaminated surfaces.
Rapid response to emerging infectious diseases
- New and evolving threats like SARS-CoV-2, avian flu, or antibiotic-resistant bacteria require fast genetic characterization.
- Higher RNA yield improves metagenomic surveillance, allowing researchers to detect novel pathogens before they spread
Forensic biocrime investigations
- Tracing the origin and dispersal of biological weapons or accidental lab leaks depends on extracting DNA from minute environmental samples.
- More recovered genetic material allows for better microbial forensics, helping agencies pinpoint sources and prevent future threats
Environmental surveillance and biohazard monitoring
- Continuous monitoring of air, water, and food supply chains for biological contaminants is essential for national security.
- Higher DNA recovery improves the detection of engineered biothreats, viral mutations, and unknown microbial hazards.
Countermeasures and vaccine development
- Biodefense labs working on vaccines and therapeutics for potential bioterror threats require high-integrity viral RNA for drug screening.
- More RNA recovery speeds up vaccine production, therapeutic research, and biodefense preparedness.
How does the Yamato Multi Beads Shocker stand up to Company Q Unit
| Multi Beads Shocker | Company Q | What does this mean to you? | |
| Paper publications | Many articles published in Nature and other journals. | No reported publications. | More peer-reviewed validation for the Multi Beads Shocker suggests a stronger scientific track record and proven reliability. |
| Materials for pulverizing | Works with various materials, including cold storage-compatible metal cones and specialized beads for different sample types. | Limited to spherical beads, mainly for microorganisms. | The Multi Beads Shocker is more versatile, allowing for a wider range of sample types, including tougher materials like animal and plant tissues. |
| Pulverizing method | Patented 3D figure eight motion, applying impact and shear force for rapid, efficient pulverization. | Linear reciprocating motion (left-right movement). No patents. | The Multi Beads Shocker’s 3D motion provides better sample homogenization and efficiency, reducing inconsistencies. |
| Rapid freezing and pulverizing (5–10 sec) | Yes, with a metal cone that prevents heat buildup and sample denaturation. | No specific heat control; uses spherical beads that generate heat. | Lower heat generation in the Multi Beads Shocker means better preservation of DNA, RNA, and proteins, crucial for molecular biology applications. |
| Rapid emulsion creation at low temperature (10–30 sec) | Yes, using the cooling effect of the metal cone. | No cooling; heat from bead collisions prevents low-temperature emulsification. | The Multi Beads Shocker is better for applications requiring low-temperature emulsification, such as lipid and protein extractions. |
| Sample tube cooling (0.0–4.0°C) | Yes, when connected to an external chiller. | No temperature control. | Our tissue homogenizer prevents sample degradation by maintaining cold temperatures, making it superior for sensitive biological samples. |
| Counterbalance | Not required; can run a single sample tube. | Required; cannot run just one sample tube. | The Multi Beads Shocker offers greater flexibility, especially for labs processing small sample batches. |
| Motor RPM | 0 - 4500 rpm with adjustable settings. | 180 - 1800 rpm, set in 180 rpm increments. | Our tissue homogenizer offers finer control and a wider speed range, allowing for more precise processing of different sample types. |
| Motor control and safety | High-precision computer control with automatic recovery, self-diagnosis, and additional software options. | Single-phase AC motor, 185W, preset at 180 rpm increments. | The Multi Beads Shocker offers smarter motor control, safety features, and flexibility for a variety of applications. |
| Backup function | Yes. Can pause and resume at any time, even after power outages. | No backup function. | Prevents loss of progress in long-running experiments, reducing sample waste and saving time. |
| Parameter setting display | Full digital display (real-time values for rpm, time, and cycle). Adjustable rotation by 1 rpm. | Basic digital display (only shows programmed settings). | The Multi Beads Shocker provides more precise control and real-time monitoring, making it easier to optimize experiments. |
| Sample tube capacity | 2ml: 8-24, 3ml: 8-18, 10ml: 4, 22ml: 4, 50ml: 4, 100ml: 2 (optional), 96-well plates: 2 (optional). | 2ml: 48, 5ml: 32, 96-well plates: 2. | Company Q holds more 2ml and 5ml tubes. The Multi Beads Shocker supports larger tubes, making it better for processing bigger sample volumes. |
| Noise level | Extremely quiet (<40dB). Like a library. | Less quiet (71.4dB). Like an air conditioner. | The Multi Beads Shocker is significantly quieter, making it more suitable for shared lab spaces and prolonged operation. |
| Cleanup for sample tube chamber | Stainless steel sink with drain port for easy cleaning. | No drain port. | The Multi Beads Shocker allows for easier and faster cleaning, reducing contamination risk. |
What does this mean in the pantheon of tissue homogenizers?
The Yamato Multi Beads Shocker gives you…
Better sample preservation
The cooling system and reduced heat generation of the Multi Beads Shocker protect DNA, RNA, and proteins, making it superior for molecular biology applications.
More versatility
Supports a wider range of sample types, including larger sample tubes and tougher materials.
Greater user control
Adjustable speed (0 - 4500 rpm), real-time digital monitoring, and backup functionality make it more precise and reliable.
More convenience
No counterbalance required, quieter operation (<40dB), and easier cleaning improve usability.